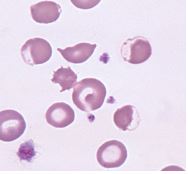

Gençlik döneminde yumuşak doku ve kemiklerin aşırı büyümesiyle karakterize kronik bir endokrin bozukluğudur. Köpeklerde 1980’de saptanmakla birlikte, daha önce akromegalinin klinik bulgulanm akla getiren kısırlaştırılmamış […]
ERİŞKİNLERİN HİPOSOMATROPİZMİ
Endokrinolojik yönden inaktif, nonfonksiyonel hipofiz tümörleri sebebiyle köpek ve kedilerde görülür. Çoğunlukla ergin yaşlı bireylerde rastlanır. Pomeranian, poodle, terrier ve chow chow gibi ırklarda gözlenir. […]
ASCARİDİOSİS (Toxocara canis, kedi de ise T.cati ve leonine)
3 aylıktan küçüklerde en çok gözükür. Siklusu 2,5-3 ay olan bir parazit nasıl oluyorda 1,5-2 aylık bir köpekte erişkin bir parazit olarak görülebiliyor? Çünkü galaktojen […]
Eksentrosit
Eksentrositler, hemoglobinin hücrenin bir kenara kayması, sentral renk alma özelliğinin kaybolması ve membran tarafından çevrilen açık bir halka görünümü ile karakterizedir.(şekilde gösterilmiştir) Köpeklerde eksentrositler, oksidatif […]
Akantosit
Eritrositlerin yüzeyine değişik uzunlukta ve çapta yüzeye eşit dağılmamış ve düzensiz yerleşmiş spiküller varsa bu hücrelere akantositler veya mahmuz(spur) hücreleri denir. Akantositlerin eritrosit membranındaki fosfolipid […]
Aglütinasyon
Eritrositlerin kümeler halinde yığılmaları aglütinasyon olarak adlandırılır. Eritrosit yüzeylerine bağlanmış olan immunglobulinler nedeniyle oluşur(immun aglütinasyon). İmmun aglütinasyon eritrositlerin kümeleşmesinin makroskobik olarak veya mikroskobik olarak görülmesiyle […]
Makrositozis
Çapı normalden daha büyük olan eritrositlere makrositler adı verilir. Rejeneratif anemiye yanıt olarak görülebilir. Ayrıca kedilerde feline leukemia virus enfeksiyonu, konjenital diseritropoietik sendrom (boynuzsuz Hereford […]
Poikilositozis
Eritrosit şeklindeki değişiklikleri tanımlayan genel bir terimdir. Polikilositozis artmış eritrosit frajilitesini veya eritrosit fragmentasyonuyla karakterize hastalıkları gösterir. Köpeklerde şiddetli demir eksikliği anemisi poikilositozise neden olabilir. […]
Nocardiosis
TANIM Nocardiosis, Nocardia spp.’ye bağlı piyogranülomatöz bir enfeksiyondur. Etkilenen sistemler: solunum, deri / ekzokrin, lenfatik, kas-iskelet sistemi, sinirdir. ETİOLOJİ VE PATOGENES Nocardia spp. yaralanma ile […]
Aktinomikoz
Özellikler Aktinomikoz, oral kavitede bulunan normalde patojenik olmayan bir aktin olan Actinomyces’in kasıtsız olarak dokuya inoküle edildiği bir hastalıktır. Enfeksiyon bölgesinde önceki bir ısırma ya […]